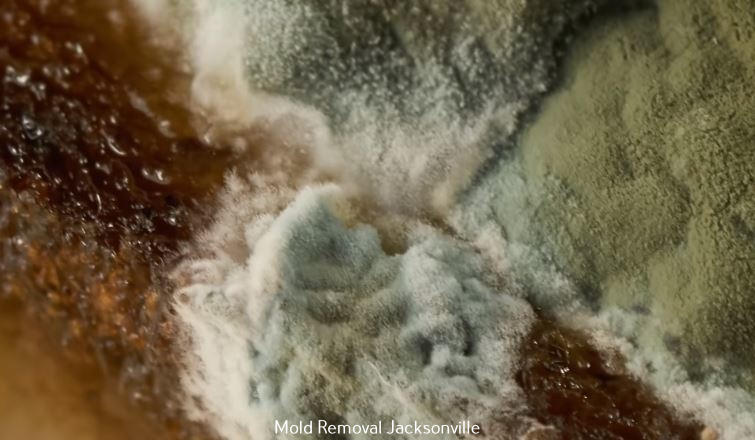

Jacksonville, NC - Hero Mold Company outlined the type of services they offer. With their many years of experience and a commitment to excellence, the leading Mold Remediation Company, Jacksonville, has emerged as a trusted service provider. The company uses cutting-edge technology and proven techniques to identify, contain, and eliminate mold growth, ensuring healthy and safe indoor environments.
The certified experts use a systematic method to deal with mold issues comprehensively. Starting with meticulous inspection and evaluation, they identify the degree of mold infestation and its underlying causes. Using modern techniques like infrared technology and air quality testing, they identify unknown mold colonies and assess air quality. This allows them to create a customized remediation strategy to meet every customer’s needs.
The remediation procedure comprises containment to prevent the further spread of mold spores, thorough removal of mold-infested items, professional cleanup, and disinfection. The top-rated Mold Removal Company in Jacksonville follows industry best practices and regulatory standards to offer quality services that exceed client expectations.
In addition to mold remediation, the top-rated Mold Company Jacksonville provides comprehensive solutions, including water damage restoration, indoor air quality improvement, and moisture control, to address the cause of mold growth and stop further infestation.
About Hero Mold Company
Hero Mold Company is a top-rated mold remediation company serving commercial and residential clients. We are determined to provide customer satisfaction and excellence and offer comprehensive mold remediation services, water damage restoration, and moisture control.
Media Contact
Hero Mold Company
130 Coastal Ln STE C, Jacksonville, NC 28546
(910) 601-2929
Media Contact
Company Name: Hero Mold Company
Contact Person: Patrick Booth
Email: Send Email
Phone: (910) 601-2929
City: Jacksonville
State: North Carolina
Country: United States
Website: https://heromoldcompany.com/mold-testing-inspection-services-in-jacksonville-nc/